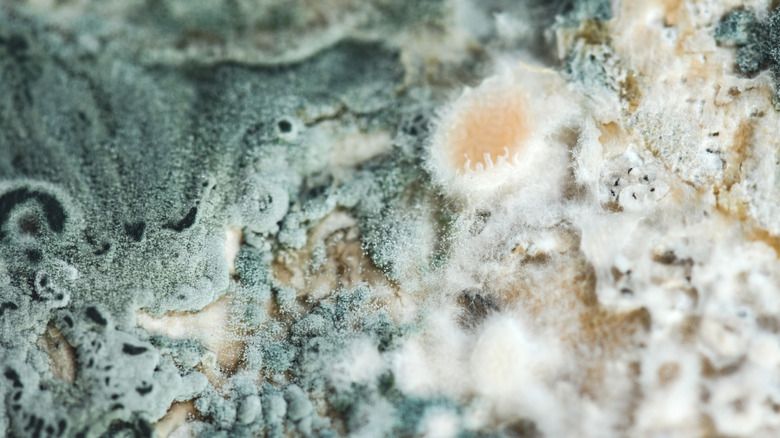
A closeup of blue-green, white fuzzy mold on bread

If You See Even A Little Mold On Bread, It's Time To Toss It
Avoiding food waste is typically a good thing. Cutting a soft spot out of a peach or trimming mold from the end of hard cheese feels like small, thrifty victory, but bread is where the cut-and-carry-on approach stops working. If you see mold on the crust, the problem isn't confined to that blue-green patch. Bread's soft, airy interior is an open network for mold's root-like filaments, called hyphae, which are microscopic fungi, and they can extend far beyond any visible bloom. Severing the offending chunk won't necessarily help, because hyphae can run invisibly through the interior long before they erupt on the surface.
The USDA advises avoiding bread, or any soft foods, with visible mold for this reason. Unlike a firm apple or block of cheddar, where you can cut a generous margin around the spot, bread doesn't offer a safe buffer zone. Mold can weave deeply and invisibly, carrying millions of spores with it. While not all bread molds are dangerous, some can produce mycotoxins, which may cause illness in humans and pets. Others trigger allergic responses even in small amounts.
It may be tempting to slice off the corner and salvage the rest, especially when the loaf is only a few days old or came from a fancy bakery. But frugality ends where safety begins. Tossing it might sting, but it's cheaper than a trip to urgent care, and better than discovering halfway through a bite that your toast tastes like a damp basement.
What is the mold that appears on bread?
Mold is a living organism with a singular job: decomposition, or breaking down organic matter so it can be recycled. It does this by sending out branching hyphae that secrete enzymes which in turn digest whatever they grow through, then produce spores to spread further. For mold, bread is an almost perfect habitat; a moist enough substrate to sustain growth, soft enough to penetrate easily, and full of starches and sugars that act as a ready food supply. When stored in sealed plastic bags, bread traps enough humidity to keep mold happy and hydrated, especially in warm kitchens. Pre-sliced, soft, sandwich-style bread is more vulnerable than a rustic boule with only one end cut — once the loaf is sliced, more of that soft, moisture-rich crumb is exposed to air, providing prime real estate for mold to take hold.
Storage myths also add confusion. Refrigeration does slow mold growth, but it speeds up staling because the cold changes the bread's starch structure, making it firm and dry. You might think drier bread can't mold, but mold spores can survive and grow in low-moisture environments, it just takes longer. Preservatives are added in commercial bread slow the process but don't stop it. Every time you open the bag, you're potentially introducing invisible, airborne spores from your kitchen to the multiple cut surfaces, which is another reason sliced loaves can mold faster than unsliced ones.
How to prevent bread from developing mold
The easiest way to avoid mold is to buy the amount of bread you can finish within a few days. Keep it cut side down in a cool, dry place away from heat sources like ovens, dishwashers, or sunny countertops. Bread boxes made for this exactly purpose. For longer storage, slice the loaf and freeze it. Frozen bread thaws quickly and toasts beautifully, retaining more of its original texture than bread that's been sitting out for a week. Crusty breads like baguettes or boules can be stored in paper bags to allow airflow, which slows mold growth, though they will dry out faster. This works best when you plan to eat them within 24–48 hours. Cloth bread bags offer a middle ground, allowing some air circulation while reducing moisture loss. For ultra-short-term storage, wrapping bread in a tea towel can also help balance airflow and freshness.
Traditional preservation methods, like naturally leavened sourdough or dense rye breads, resist mold longer because their acidity and structure make them less hospitable to mold. Still, no bread is immune. Mold spores (and other bacteria) are everywhere, on counters, in the air, even on your hands, so once a loaf is exposed, the clock starts ticking.
If you're serious about waste prevention, portion your bread purchases and rotate your stock, as restaurants do. And if a loaf does cross the line, compost it or feed it to chickens, but skip the toast.